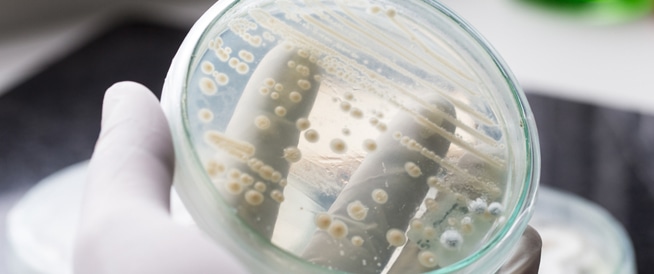

الفطريات المهبلية
Share your love
الفطريات المهبلية
Vaginal Yeast Infection

الفطر المهبلي، والمعروف أيضا باسم “المبيضة في المهبل” (Vagainal candida) أو “داء المبيضات” (Candidiasis) – إحدى الظواهر الشائعة لدى النساء، وفي غالبية الحالات تكون سهلة العلاج. المُبْيَضَّة (Candida) هي جِنْسٌ من الفُطْرِيَّاتٍ. وهي تتواجد، بشكل عام، بكميات صغيرة في المهبل (Vagina)، في الفم وفي الجهاز الهضمي. عندما تزداد الفطريات في المهبل أكثر من الوضع الطبيعي، ينشأ تلوث فطري (Fungal infection) {خلايا خميرية}.
نتيجة لذلك، تظهر أعراض غير مرغوب فيها، مثل الحكة في المهبل، الشعور بحرقة وإفرازات مهبلية.
مرض السكري غير المضبوط وتناول المضادات الحيوية (Antibiotics)، استعمال الإسفنجة المهبلية لمنع الحمل (Contraceptive sponge)، العازل الأنثوي لمنع الحمل (Diaphragm) والمواد قاتلة للحيوانات المنوية كطرق لمنع الحمل – من شأنها أن تسبب تلوثات (التهابات) فطرية في المهبل بوتيرة مرتفعة جدا. النساء اللواتي يستعملن العلاج الهرموني لمنع الحمل، حبوب منع الحمل، لاصقات منع الحمل أو الحلقة المهبلية (Vaginal ring) هن أكثر عرضة للإصابة بتلوث فطري في المهبل.
أعراض الفطريات المهبلية
تعاني ما بين 5% – 8% من النساء من ظهور داء المبيضات في المهبل (الفطريات المهبلية – Vulvovaginal candidiasis). تتمثل هذه الظاهرة بظهور أعراض مشابهة لأعراض التلوث الفطري في المهبل، أربع مرات أو أكثر خلال فترة 12 شهرا.
بالرغم من أن ظهور الفطر المهبلي هو أكثر انتشارا بين النساء المصابات بمرض السكري ولدى النساء اللواتي تعانين من مشاكل في الجهاز المناعي (Immune system)، إلا إن غالبية النساء المصابات بالفطر المهبلي لا تعانين من مرض محدد من شأنه أن يسبب تلوثا فطريا متكررا في المهبل.
أسباب وعوامل خطر الفطريات المهبلية
ثمة أمراض يتم تشخيصها، خطأ، على أنها مرض الفطر المهبلي، وهي: البكتيريا المهبلية (Bacterial vaginosis) والتهاب المهبل بالمشعرات (Trichomonas vaginitis).
يمكن للفطر المهبلي أن ينجم عن البكتيريا المهبلية (Bacterial vaginosis) – وهذا هو السبب الأكثر انتشارا لالتهاب المهبل عند النساء في سن الخصوبة – وعن التهاب المهبل بالمشعرات، وعن الأمراض المنقولة جنسيا (Sexually transmitted diseases).
البكتيريا المهبلية والتهاب المهبل بالمشعرات يرتبطان بمشاكل أشد صعوبة في جهاز الأعضاء التناسلية، مثل ولادة الخدج وكثرة الإصابة والعدوى بالأمراض المنقولة جنسيا.
استنادا إلى حقيقة أن أعراض الأمراض المعدية هذه مشابهة لأعراض الفطر المهبلي (لكن مضاعفاتها أشد) فمن المهم التوجه إلى الطبيب من أجل إجراء فحص يتم خلاله تقييم وتشخيص أية علامات وأعراض في المهبل، كل منها بحد ذاته. هنالك الكثير من الأدوية لمعالجة التلوثات في المهبل، لكن المفتاح لنجاح العلاج هو التشخيص الصحيح.
تشخيص الفطريات المهبلية
إن حقيقة كون ظهور الفطر في المهبل يشكل ظاهرة واسعة الانتشار، هي السبب – على ما يبدو – في أن نساء كثيرات يقمن، في كثير من الأحيان، بتشخيصها ومعالجتها بشكل ذاتي بأنفسهن، بواسطة مستحضرات لا تحتاج إلى وصفة طبية.
لكن التشخيص الذاتي قد يكون خاطئا. فقد أظهر أحد الأبحاث أن 11% فقط من النساء استطعن تشخيص المبيضة (Candida) في المهبل بشكل دقيق، بينما 35% فقط من النساء اللواتي أصبن بتلوث الفطر المهبلي استطعن تشخيص الوضع بشكل دقيق. هنالك أشكال وأنواع كثيرة من عدوى (تلوث) المهبل تسبب الأعراض نفسها، مثل البكتيريا المهبلية والتهاب المهبل بالمشعرات.
الاعراض التي يسببها الفطر المهبلي
- الوجع و/أو الحكة في المهبل.
- إفرازات لزجة، تشبه الجبنة، من المهبل تنبعث منها، أحيانا، رائحة خميرة (yeast). الرائحة النتنة هي علامة على وجود البكتيريا المهبلية وليس على وجود فطر مهبلي. يفرز المهبل، عادة، مادة غالبا ما تكون صافية، أو معكرة بعض الشيء، لكنها لا تسبب الحرقة وتنبعث منها رائحة خفيفة. بالإضافة إلى ذلك، فثمة حالات لا يكون فيها التلوث الفطري في المهبل مصحوبا بأية إفرازات، أو يكون مصحوبا بإفراز مائي زائد السيولة.
- الشعور المزعج بالحرقة حول فتحة المهبل، وخاصة عندما يلامس البول هذه المنطقة.
- احمرار وانتفاخ في منطقة الفرج (Vulva) والمهبل.
يوصى بإبلاغ الطبيب في حال ظهور أي من هذه الأعراض.
خلال فترة الحيض (الدورة الشهرية)، تتغير كمية ووتيرة الإفراز من المهبل. في فترة معينة خلال الشهر يمكن لهذا الإفراز أن يكون أقل لزوجة، أو مائيا جدا حتى، بينما في فترات أخرى خلال الشهر يمكن أن يكون أكثر لزوجة. هذه التغيرات هي طبيعية. يكون الإفراز العادي، خلال فترة الدورة الشهرية، سلسا.
وعلى أية حال، فإن أي إفراز من المهبل يكون مصحوبا برائحة كريهة ويسبب تحفيزا (تهيجا) هو ظاهرة غير طبيعية. قد يظهر التهيج بشكل حكّة، حرقة، أو كلتيهما معا، وفي كثير من الأحيان تزداد هذه خلال ساعات الليل. كما يزيد الجِماع، عادة، من حدة هذا التهيج.
تشخيص الأعراض المهبلية
من أجل تشخيص الأعراض المهبلية، ينبغي على طبيب النساء أن يفحص ما إذا كان هنالك التهاب في المهبل أو إفراز غير طبيعي منه. في حالات معينة، ينبغي عليه إرسال عينة من الإفراز المهبلي إلى الفحص المخبري تحت المجهر، أو إجراء فحص زرع (استنبات – Culture) للفطر والذي يتم من خلاله فحص ما إذا كانت سينمو فطر المبيضة (Candida) على هذا الإفراز، في ظروف المختبر.
يساعد الفحص المجهري، أحيانا، في نفي وجود مسببات أخرى للإفراز، مثل البكتيريا المهبلية أو التهاب المهبل بالمشعرات، والتي تتطلب علاجا مختلفا.
علاج الفطريات المهبلية
للوقاية ومنع ظهور الفطر المهبلي، يتم استخدام الأدوية المضادة للفطريات (Antifungal drugs). هنالك العديد من هذه الأدوية، والتي لا تتطلب وصفة طبية. بالإضافة إلى ذلك، هنالك أدوية يجب تناولها لمدة يوم واحد، ثلاثة أيام أو سبعة أيام.
أدوية لعلاج الفطريات المهبلية
- بوتوكونازول (Butoconazole)
- تيركونازول (Terconazole)
- تياكونازول (Tioconazole)
- مايكونازول (Miconazole)
- كلوتريمازول (Clotrimazole)
الفوارق بين الأدوية المختلفة التي تباع دون وصفة طبية هي مدة العلاج، نوع المستحضر وسعره. العلاجات القصيرة تكون، عادة، مريحة أكثر، لكن سعرها أغلى. الأدوية الذي يجب تناولها لمدة يوم واحد، لمدة ثلاثة أيام أو لمدة سبعة أيام تتمتع بنفس مستوى النجاعة. بالإضافة إلى ذلك، هنالك أدوية تستلزم وصفة طبية.
بشكل عام، من المقبول والمتبع، عادة، استخدام الأدوية المضادة للفطريات التي لا تحتاج إلى وصفات طبية لمعالجة أعراض التلوث الفطري بشكل ذاتي، إذا كان هذا التلوث قد ظهر من قبل وتم تشخيصه من قبل الطبيب سابقا، والأعراض التي تظهر الآن، مرة أخرى، هي نفسها التي ظهرت في السابق.
ولكن، في الحالات التالية تـُمنع المعالجة بشكل ذاتي، بل يجب التوجه لاستشارة الطبيب:
- عدوى فطرية لم تظهر من قبل في الماضي.
- حمى وأوجاع في البطن.
- الإفراز من المهبل يبعث رائحة كريهة جدا.
- لدى النساء المصابات بمرض السكري، النساء اللواتي لديهن فيروس العوز المناعي البشري (فيروس الإيدز – HIV) إيجابي، النساء الحوامل أو المرضعات.
- تم، من قبل، استخدام دواء مضاد للفطريات بدون وصفة طبية لمعالجة الفطر، لكن الأعراض لم تختف، أو عاودت الظهور فورا.
عند استخدام أدوية لمعالجة الفطر المهبلي، سواء كانت أدوية تحتاج إلى وصفة طبية، أو بدونها، يجب الحرص على تناول الجرعة بالكامل. يُمنع التوقف عن تناول الدواء إذا لم تستجب الأعراض للدواء، أو في حال ظهرت فورا بعدما اختفت من قبل، حتى وإن طرأ تحسن في الحالة.
في حالة عدم استجابة الأعراض للدواء، أو في حالة ظهورها مجددا فور اختفائها، يجب استشارة الطبيب. لا يفضل محاولة حل المشكلة بواسطة استخدام دواء بدون وصفة طبية، لأن الأعراض قد تكون ناجمة عن مسبب آخر مختلف، وليس عن عدوى فطرية.
وقد أظهرت الأبحاث أن نسبة التشخيصات الذاتية الخاطئة للتلوثات الفطرية تصل إلى نحو 89%. وهذه نسبة مرتفعة جدا. إذا لم تختف الأعراض، أو إذا عاودت الظهور فورا بعد أن اختفت، فعندئذ يجب التوجه إلى الطبيب. من المهم التذكر بأن التهيج في المهبل وفي الفرج قد يستمر نحو أسبوعين. ويمكن للعدوى الفطرية أن تزول وتختفي من دون أي علاج. وفي كل الأحوال، فإن احتمال (خطر) تفاقم العدوى الفطرية إلى عدوى أشد خطورة، وهي المسماة بداء المبيضات المجموعي (Systemic candidiasis)، هو احتمال منخفض جدا. هذه المضاعفات تنشأ لدى النساء اللواتي تعانين من ضعف في الجهاز المناعي.
الآثار الجانبية للادوية
الآثار الجانبية للأدوية التي يمكن اقتناؤها بدون وصفة طبية تكون خفيفة، عادة، وتشمل: الحرقة، الحكة، الطفح الجلدي والصداع. بالإضافة إلى ذلك، وكما هو الحال بالنسبة إلى أي دواء، من الممكن أن تظهر، في حالات نادرة، آثار جانبية شديدة، بينها الشرى (“الشرية” – مرض جلدي – Urticaria)، ضيق التنفس وانتفاخ الوجه. في حال ظهور إحدى هذه الآثار، يجب التوجه للحصول على استشارة طبية فورية.
الأدوية المضادة للفطريات يمكن أن تمس بنجاعة وفاعلية العازل الذكري (Condom) والعازل الأنثوي لمنع الحمل (Diaphragm). لذلك، ينبغي عند تناول هذه الأدوية استخدام طرق أخرى لمنع الحمل والوقاية من الأمراض التي تنتقل جنسيا. كذلك، يفضل عدم استخدام الدحسة (السدادة – Tampon) التي يتم إدخالها إلى المهبل خلال فترة استخدام أدوية معالجة الفطر.
في حالات معينة، يوصي الطبيب بتناول دواء الفلوكونازول (Fluconazole) {ديفلوكان – Diflucan}، تتم المعالجة به عن طريق الفم ويحتوي على جرعة واحدة فقط. يوصى بعدم تناول هذا الدواء خلال فترة الحمل. كما يُمنع تناول الفلوكونازول (Fluconazole) مع السيسابريد (Cisapride) {بريبولسيد – Prepulsid} لأن الدمج بين هذه الأدوية من شأنه أن يسبب مشاكل خطيرة في القلب، أو حتى الموت.
في حالات نادرة، قد يسبب الفلوكونازول ضررا في الكبد، يكمن أن ينتهي بالموت. وبالإضافة إلى ذلك، يجب إبلاغ الطبيب فورا في حال ظهور الطفح (Rash) خلال استعمال الفلوكونازول.
أعراض جانبية إضافية، أكثر انتشارا وأقل حدة، يمكن أن تشمل:
- الإسهال
- الصداع
- الدوخة
- وجع البطن
- حرقة الفؤاد (Heartburn)
الوقاية من الفطريات المهبلية
يمكن الوقاية من الفطر المهبلي عن طريق مراعاة عدة تدابير والالتزام بها:
- الحفاظ على نظافة وجفاف المنطقة الخارجية من الجهاز التناسلي.
- الامتناع عن استعمال الصابون الذي يسبب التهيج (وخاصة رغوة البانيو) وعن استعمال الرذاذات المهبلية.
- الامتناع عن استعمال الصابون، المساحيق وأوراق التواليت المعطرة.
- الامتناع عن الاستعمال اليومي لفوط الحماية، لأنها تحصر الرطوبة وتمنع تدفق الهواء.
- تبديل الدحسة (السدادة – Tampon) والفوط اليومية.
- ارتداء ملابس داخلية قطنية غير ضيقة، لا تحصر الرطوبة.
- تبديل الملابس الرطبة بملابس جافة فورا بعد السباحة.
- الحفاظ على مستوى متوازن من السكر في الدم لدى المصابات بالسكري.
- استعمال المضادات الحيوية فقط في الحالات التي يصف فيها الطبيب ذلك، وعدم تجاوز توجيهاته. المضادات الحيوية تقضي على الجراثيم التي تسبب الأمراض وعلى الجراثيم المفيدة التي تحافظ على مستويات طبيعية للفطريات في المهبل. المرأة التي تصاب بالفطر المهبلي في كل مرة تتناول فيها مضادا حيويا، من المفضل أن تطلب من الطبيب إضافة دواء مضادات الفطريات بالإضافة إلى المضادات الحيوية.
- بعد نشاط معوي، أو إفراز البول، يجب التجفيف من القسم الأمامي باتجاه القسم الخلفي (من المهبل وليس إليه).
- يجب عدم غسل المهبل بواسطة الحامض أو بواسطة مواد كيماوية، لأن هذا يرفع من نسبة التلوث والعدوى في المهبل، لأن الأحماض والمواد الكيماوية تضر بتوازن الجراثيم في المهبل.


.jpg)



